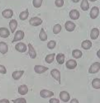

L10: When Haemopoiesis Goes Wrong Flashcards
(32 cards)
What are myeloproliferative neoplasms?
What are they caused by (generally)?
What is the specific point mutation?
Myeloproliferative neoplasms are a group of diseases of the bone marrow in which excess blood cells are produced. (CANCER)
Caused by genetic mutations in/dysregulation of the mulipotent haemopoietic stem cell.
Specific point mutation in one copy of Janus Kinase 2 (JAK2) gene on chromosome 9
Describe the normal role of JAK 2 and what happens if it is mutated as in myeloproliferativ neoplasms
- JAK2 codes for cytoplasmic tyrosine kinase which normally stimulates signalling pathways in response to erythropoietin
- If have JAK2 mutaion then multipotent stem cells survive longer and proliferate continously
State and briefly descirbe the 4 major types of myeloproliferative neoplasms
- Polycythaemia vera: excess RBCs
- Essential thrombocythaemia: overproduction of megakaryocytes leading to excess platelets
- Primary myelofibrosis: initial proliferative stage followed by replacement of heamopoietic tissue by conenctive tissue leading to impairment of generation of all blood cells leading to pancytopenia
- Chronic myeloid leukaemia: excess granulocytes
Do myeloproliferative neoplasms have potential to transform into acute leukaemia?
Yes
What is polycythaemia?
Increase in circulating RBCs/volume percent of erythrocytes increases aboe 0.52 for males and 0.48 for females.
State 2 potential causes for polycythaemia
- Increased number of erythrocytes = absolute polycythaemia
- Decrease in plasma volume (but with normal number of erythrocytes)= relative polycythaemia
Absolute polycythaemia (increased number of erythrocytes) can be further classified in to primary and secondary; describe each
- Primary: abnormality originates in bone marrow/genetic mutation. Only diagnosis is polycythaemia vera
- Secondary: caused by increased levels of EPO may be physiologically appropriate or inapporiate and due to an abnormal cause

Give some examples of abnormal/physiologically inappropriate causes of secondary absolute polycythaemia

What is polycythaemia vera?
What mutation do 95% of patients have?
Is it equally common in both genders?
Median age?
Specific form of polycythaemia arising from a myeloproliferative neoplasm in bone marrow resulting in overproduction of RBCs.
- Mutation in JAK2 gene
- Equally common in both genders
- 60
State at least 5 (out of 10) symptoms of polycythaemia vera
- Thrombosis
- Haemorrhage
- Headache & dizziness
- Gout
- Splenomegaly
- Pruritis
- Erythromelalgia (burnin pain in hands and feet)
- Arthritis
- Plethora of blood
- Potential to transform into myelofibrosis or acute leukaemia
State 3 possible treatments for polycythaemia vera
- Venesection (maintain Hct <0.45)
- Aspirin (antiplatelet effects)
- Cytoreduction using agents e.g. hydroxycarbamide (inhibits DNA synthesis. Used if patient has poor tolerance of venesection or shows severe symptoms or progressive splenomegaly or disease progression e.g. night sweats, weight loss)
NOTE: cytoreduction= to reduce cell number
What is thrombocythaemia?
Increase in platelet count
Describe the 3 types of thrombocythaemia
- Primary: abnormality originates in bone marrow/genetic mutation e.g. essential thormobcythaemia
- Secondary: normal bone marrow response to extrinsic factors
- Redistributional: platelet redistributed from splenic pool into blood)

What must you do before you can diagnose primary/essential thrombocythaemia?
Investigate and exclude secondary and redistrubtional causes to determine if elevated platelets in persistent or transient e.g. infection, inflammation, cancer, haemorrage, redistrubtion post spleenectomy or hyposplenism
What is essential thrombocythaemia?
What percentage of patients have JAK2 mutation?
What other mutations, other than JAK2, may be present?
- Rare chronic blood cancer characterised by overproduction of platelets from megakaryocytes (which may be large and in excess also)
- 50%
- CALR mutations or mutation in thrombopoietin receptor
State 4 (out of 5) symptoms of essential thrombocythaemia
- Erythromelalgia
- Disturbances in hearing or vision
- Numbness in extremeties
- Thrombosis (leading to stroke, peripheral gangrene)
- Headaches
When deciding how to manage essential thrombocythaemia patients are grouped into low and high (>60yrs, platelet >1500, disease-related thrombosis or haemorrhage) risk; state plan for low and high risk
- Low: aspirin
- Aspirin & hydroxycarbamide (or other treatment to reduce cell count)
What is primary myelofibrosis?
Is JAK 2 mutation associated with disease?
A myeloproliferative neoplasms where the proliferation of mutated haemopoetic stem cells results in reactive bone marrow fibrosis leading to replacement of bone marrow with scar tissue
JAK2 mutation associated with disease
Why is splenomegaly and hepatomegaly often seen in primary myelofibrosis?
Mutated haemopoietic cells can mobilse out of bone marrow and colonise in liver and spleen
What type of cells can be seen on blood film in essential myelofibrosis?
Tear drop shaped cells as they have squeezed out of fibrotic marrow
State 5 (out of 9) symptoms of primary myelofibrosis
- Hepatosplenomegaly (can lead to satietym pain, splenic infarct)
- Bruising
- Fatigues
- Weight loss
- Fever
- Increased sweating
- Portal hypertension
- Early death
- Potential to transform into leukaemia
State 5 possible treatments for primary myelofibrosis
Do the treatments help survival?
Treatment largely supportive and only has median survival rate of 5 years.
- Hydroxycarbamide
- Folic acid supplements
- Blood transfusions
- Splenectomy
- Ruxolitinib (inhibits JAK2)
Leukaemia can be acute or chronic; explain difference
- Acute: rapidly cause bone marrow failutre due to large number of immature blast cells inhibiting abilty of tissue to produce mature blood cells
- Chronic: slower onset of symptoms and progression and the malignant clonal cell is often differentiated/matured
